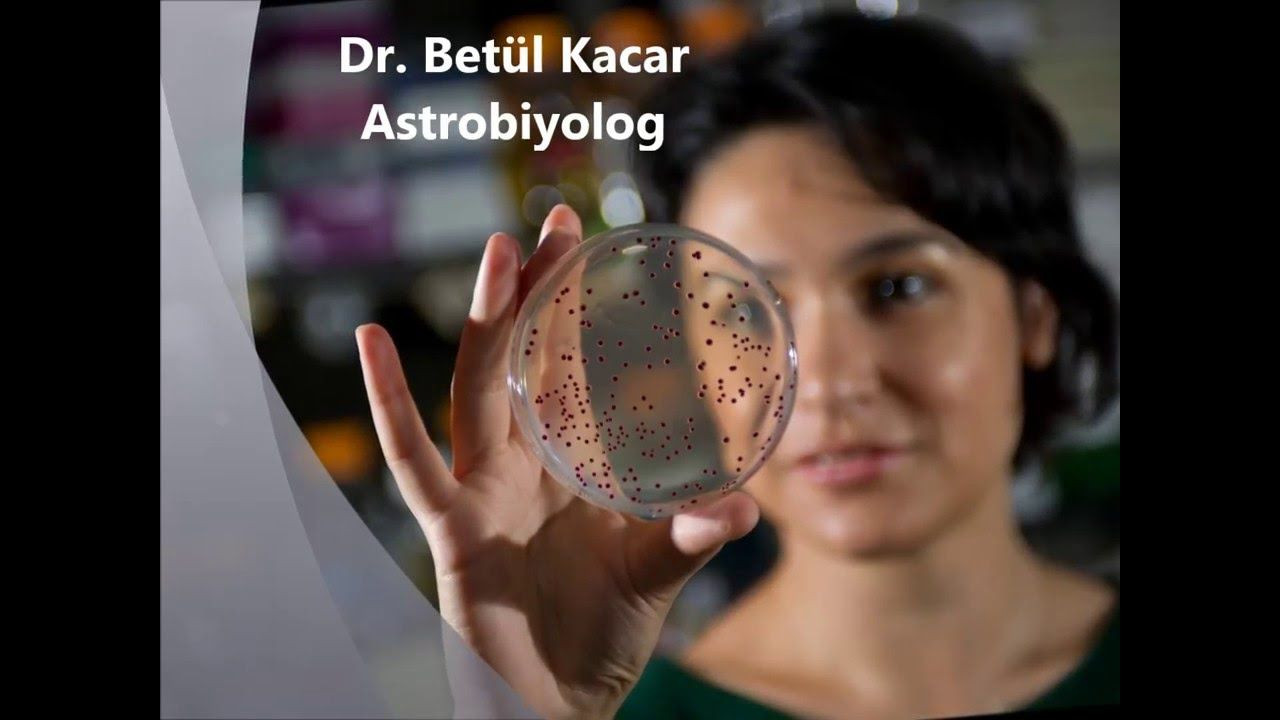
Türk bilim kadını NASA'ya kabul edildi! Evrende yaşamı araştıracak... - Sayfa 7

ABD’deki Arizona Üniversitesi’nde Astronomi ve Moleküler Hücre Biyolojisi departmanında görev yapan Türk bilim insanı Betül Kaçar, güzel haberi Twitter hesabından paylaştı...
Türk bilim kadını NASA'ya kabul edildi! Evrende yaşamı araştıracak...
Türk bilim insanı Betül Kaçar, Türkiye'yi gururlandıran gelişmeyi Twitter'dan duyurdu. Astronomi ve moleküler hücre biyolojisi üzerine çalışmalar yapan Kaçar, NASA’nın evrendeki yaşam izlerini araştırmak için kurduğu ekibe dahil edildiğini açıkladı. Astrobiyolog Kaçar'ın başarısı sosyal medyada büyük yankı buldu. Takipçiler Kaçar'a tebrik yağdırdı.


Kaçar gelişmeyi şu mesajla paylaştı: "Güzel bir haber. Kelimelere dökmekte zorlanıyorum ama şöyle: Evrende yaşamın izlerini araştırmak için oluşturulan yeni bir NASA ekibine kabul edilmişim. Bu seneye ufak bir sağlık sorunu ile başladım, ilaç gibi geldi bu haber sabah sabah. Her şeyin başı sağlık diyerek bitireyim."

TEBRİK YAĞDI
Bu mesajı gören pek çok kişi Kaçar’ın başarısını kutladı. Bunun üzerine 36 yaşındaki bilim insanı takipçilerine"Çok teşekkür ederim. Benden güç alanlar, özellikle çocuklar, genç arkadaşlar; siz de bana güç veriyorsunuz" sözleri ile karşılık verdi.

"KEŞİFLERİMİZ TÜM İNSANLIĞA HEDİYE"
Kaçar kendisine “Cumhuriyet çocuğu” diye hitap edenlere de şu sözlerle karşılık verdi: "Borcumuz biz kadınlara eğitim fırsatı ve eşitliği veren Cumhuriyet’e. Keşiflerimiz tüm insanlığa hediye."

'MOLEKÜLLERE AŞIK OLDUM, ÇOK ETKİLENDİM"
Betül Kaçar bu alanda çalışmaya nasıl başladığını ise şu sözlerle anlatıyor: "Türkiye'de kimya bölümünde okurken Türkiye'de uluslararası konferanslar çok fazla oluyordu. Konferanslarda gönüllü olarak çalışmaya başladım ve proteinlere, moleküllere aşık oldum, gerçekten çok etkilendim. Bilim insanlarının bir odada bilim hakkında konuşması, günlerce kendilerini kapatıp bir hastalığı çözmeye çalışması ya da aslında hayatımızı ne kadar etkileyen o çok küçük olguları algılamaya çalışmaları beni çok etkilemişti."

BETÜL KAÇAR KİMDİR?
Giresunlu bir ailenin çocuğu olan Betül Kaçar, Marmara Üniversitesi’nde kimya eğitimi gördü ve 20 yaşında eğitim amacıyla ABD’ye gitti.
20 yaşında direkt Parkinson ve Alzheimer üzerine doktora çalışmasına başlayan Kaçar, 2010’da Atlanta’daki Emory Üniversitesi’nden doktora derecesi aldı. Evrimin molelüler mekanizmalarına yönelik anlayışımızla ilgilenen Kaçar, doktora sonrası çalışmalarını NASA’da devam ettirdi.
2012 yılında Harvard Üniversitesi'ne katılan Betül Kaçar, burada Organizma ve Evrimsel Biyoloji Departmanı'nda görev yaptı. Türk bilim insanı, 2017 yılından bu yana da Arizona Üniversitesi Astronomi ve Moleküler Hücre Biyolojisi alanından çalışma yapıyor.

“NASA’nın burs verdiği ilk Türk bilim kadını” olan Betül Kaçar, NASA Astrobiyoloji Enstitüsü’nün “önde gelen üyelerinden biri” olarak da tanımlanıyor.